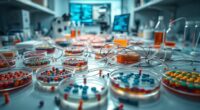
antibiotic resistance crisis

I’ve tested many luxury Egyptian cotton bedding sets, and I know the difference quality makes. The best options feature high thread counts—up to 1500—crafted from soft, long-staple fibers that feel silky and last through countless washes. They offer a perfect fit, breathability, and a luxurious finish that transforms your sleep space. Keep going to discover top brands and key features that help you choose the perfect set for a truly restorative sleep experience.
Key Takeaways
- High thread counts (300-1500) in Egyptian cotton sheets ensure softness, durability, and a luxurious feel for restorative sleep.
- Deep-pocket fitted sheets with all-around elastic provide a secure fit on mattresses up to 24 inches deep.
- The sateen weave offers a silky, breathable surface that enhances comfort and temperature regulation throughout the night.
- Certified organic and eco-friendly options guarantee safe, sustainable, high-quality bedding for restful sleep.
- Proper care, including gentle washing and folding, maintains the sheets’ softness, color, and longevity over time.

TWK 1200 TC 100% Egyptian Long-Staple Cotton Bedding Sheets Set, Luxury Hotel Style Deep Pocket with Elastic Reinforced Seams Sheet Set, Soft & Comfy Natural Sheets (White, King)
【Luxurious Feel】1200 thread count bedding crafted from 100% Egyptian long-staple cotton fibers; Silky sateen weave maintains breathable while...
As an affiliate, we earn on qualifying purchases.
TWK Egyptian Cotton Bedding Sheets Set

If you’re looking for a bedding set that combines luxurious softness with long-lasting durability, the TWK Egyptian Cotton Bedding Sheets Set is an excellent choice. Made from 100% Egyptian long-staple cotton, it offers a silky sateen weave that’s breathable and resistant to pilling. I love how it feels like hotel-quality comfort, suitable for all seasons. The fitted sheet’s deep pockets and elasticized edges guarantee a perfect fit on thick mattresses. Plus, reinforced double seams prevent tearing over time. It’s easy to care for—just machine wash and tumble dry—and backed by a one-year warranty. This set truly elevates any bedroom with its premium quality.
Best For: those seeking luxurious, durable, and breathable bedding that offers hotel-grade comfort and fits thick mattresses perfectly.
Pros:
- Crafted from 100% Egyptian long-staple cotton for softness and durability
- Breathable sateen weave resists pilling and maintains a silk-like drape
- Deep-pocket fitted sheet with fully elasticized 360° band ensures secure fit on thick mattresses
Cons:
- Slightly higher price point compared to standard cotton sheets
- May require careful washing to preserve the sateen finish and elasticity
- Limited color options, as the set is solid white for a modern look

LANE LINEN 100% Egyptian Cotton King Sheets Set – 4 Piece Sateen Weave Bed Sheets, Ultra Soft, 16" Deep Pocket, Luxury King Size Sheet Set – White
Luxurious Feel: Experience unparalleled comfort and luxury with this premium Egyptian cotton sheet set, specially designed for a...
As an affiliate, we earn on qualifying purchases.
LANE LINEN Egyptian Cotton King Sheets Set (4 Pieces)

The LANE LINEN Egyptian Cotton King Sheets Set is an excellent choice for those who prioritize hotel-quality luxury and lasting durability in their bedding. Made from 100% Egyptian cotton with a 1000-thread count, these sheets are incredibly soft, breathable, and built to last. The silky-smooth sateen weave enhances their luxurious feel, while the deep pockets and elasticized edges ensure a snug fit. The crisp white color adds timeless elegance, seamlessly fitting any bedroom décor. Easy to care for, they’re machine washable and eco-friendly, with certifications like OEKO-TEX. I love how these sheets combine comfort, style, and durability for a truly restorative sleep experience.
Best For: those seeking hotel-quality luxury, durability, and a silky-soft feel in their king-sized bedding.
Pros:
- Made from 100% Egyptian cotton with a luxurious 1000-thread count for exceptional softness and durability
- Features a silky-smooth sateen weave and timeless white color that complement any bedroom décor
- Deep pockets with elasticized edges provide a snug, secure fit, ensuring full coverage and comfort
Cons:
- Slight variations in fabric density may occur due to manufacturing tolerances
- Higher thread count sheets may require careful washing to maintain softness and longevity
- Price point may be higher compared to standard sheet sets, reflecting premium quality

800 Thread Count Queen Sheet Set,100% Egyptian Cotton Sheets Queen Size Bed Set, Silky Sateen Weave White Sheets, Ultra-Soft Durable Hotel Luxury Bed Sheets with 15" Snug Fit Deep Pockets-White
LUXURIOUSLY THICK AND BREATHABLE BEDDING SHEETS & PILLOWCASES: These exquisite Queen size sheets are thick & heavy and...
As an affiliate, we earn on qualifying purchases.
100% Egyptian Cotton Queen Size Bed Sheets Set

Those seeking a truly luxurious sleeping experience will appreciate the 100% Egyptian Cotton Queen Size Bed Sheets Set, crafted for comfort and durability. Made from 800-thread-count Egyptian cotton, these sheets are thick, breathable, and incredibly soft, with a silky sateen weave that feels luxurious against the skin. The set includes a flat sheet, fitted sheet with deep pockets, and pillowcases—all designed for all-season comfort. Certified under OEKO-TEX standards, they undergo rigorous testing to guarantee quality and safety. Customers love their durability, softening with each wash, and secure fit on deep mattresses, making them a premium addition to any bedroom.
Best For: those seeking a luxurious, durable, and breathable bedding set that offers all-season comfort and a hotel-like feel.
Pros:
- Made from 100% Egyptian cotton with an 800-thread-count for softness and durability
- Includes deep-pocket fitted sheet with elastic all around for a secure fit on various mattress sizes
- Certified under OEKO-TEX Standard 100, ensuring safety, quality, and sustainability
Cons:
- May have initial odors or sizing discrepancies that improve after washing
- Pillowcases may be slightly shorter than expected for some users
- Packaging and minor imperfections could be present, but overall quality remains high

Threadmill Egyptian Cotton Queen Sheet Set | 100% Certified Egyptian Cotton Sheets for Queen Size Bed | Queen Bed Sheets Set with Snug Fit 16" Deep Pocket | Soft Cooling Sateen Bedding Set | White
AUTHENTIC EGYPTIAN COTTON BEDDING FOR COZY AND HEALTHY SLEEP: Bid adieu to hot, sleepless nights by adding our...
As an affiliate, we earn on qualifying purchases.
Threadmill Egyptian Cotton Queen Sheet Set

Looking for luxurious bedding that combines superior quality with everyday comfort? The Threadmill Egyptian Cotton Queen Sheet Set might be exactly what you need. Made from 100% certified Egyptian cotton with extra long staple yarns, these sheets deliver exceptional softness and durability. The 400-thread count sateen weave creates a silky, smooth feel that’s perfect for restful sleep. The set includes a fitted sheet with a deep pocket, a flat sheet, and two pillowcases, all in a crisp white hue that elevates any bedroom. Certified by OEKO TEX and produced sustainably, these sheets are both eco-friendly and safe, offering a luxurious, breathable sleep experience.
Best For: those seeking luxurious, durable, and eco-friendly bedding that offers a silky, comfortable sleep experience on any queen-sized mattress.
Pros:
- Made from 100% certified Egyptian cotton with extra long staple yarns for superior softness and durability
- 400-thread count sateen weave provides a silky, smooth feel and minimal wrinkling
- Eco-friendly, sustainably produced with OEKO TEX certification, ensuring safe and environmentally responsible manufacturing
Cons:
- Some users find the fitted sheet runs smaller than expected and may not fully fit thicker mattresses
- Slight fabric thinning reported by a few, which could affect long-term durability for some
- The set may require careful washing to prevent shrinkage and maintain color and softness
THREAD SPREAD Egyptian Cotton Queen Sheets, 4 PC, 1000 Thread Count

If you’re seeking bedding that combines exceptional softness, durability, and a luxurious feel, the Thread Spread Egyptian Cotton Queen Sheets are an ideal choice. Made from 100% long-staple Egyptian cotton with a 1000 thread count, these sheets offer a silky sateen finish that’s breathable and smooth. The deep-pocket fitted sheet with elastic guarantees a secure fit on thicker mattresses, while the set includes two pillowcases and a flat sheet. Certified by OEKO-TEX, they’re safe and eco-friendly. Customers rave about their softness, durability, and cooling properties, making them perfect for restful, all-season sleep. These sheets truly elevate the bedroom experience.
Best For: those seeking luxurious, durable, and breathable bedding suitable for all seasons, especially hot sleepers and those who value high-quality Egyptian cotton.
Pros:
- Ultra-soft, silky smooth sateen finish that enhances comfort and appearance
- Deep-pocket fitted sheet with elastic for a secure fit on thicker mattresses
- Durable and long-lasting, with many users experiencing years of quality use and softness improvement over time
Cons:
- Can wrinkle after drying, requiring additional smoothing or ironing if desired
- Slightly higher price point compared to standard sheets, but justified by quality
- Some users have reported minor issues with softness after multiple washes or minor itchiness
THREAD SPREAD Egyptian Cotton King Sheets Set

The Thread Spread Egyptian Cotton King Sheets Set stands out as the perfect choice for anyone seeking hotel-quality luxury at home. Made from high-quality, extra-long staple Egyptian cotton, these sheets offer exceptional softness, durability, and a silky feel thanks to their sateen weave. The set includes a flat sheet, a fitted sheet with deep 17-inch pockets, and two pillowcases, all designed for a snug fit on even thicker mattresses. Certified by OEKO-TEX, they’re safe and free from harmful substances. With a luxurious 1500 thread count and a classic white finish, these sheets deliver an elegant, comfortable sleep experience year-round.
Best For: those seeking hotel-quality, luxurious Egyptian cotton sheets that provide comfort, durability, and a perfect fit for deep mattresses.
Pros:
- Exceptionally soft, silky feel with a 1500 thread count and sateen weave.
- Deep 17-inch pockets with elasticized edges ensure a snug fit on thicker mattresses.
- Made from high-quality, OEKO-TEX certified Egyptian cotton, ensuring safety and long-lasting durability.
Cons:
- Some users may experience shrinkage if not washed and cared for properly.
- Heavier weight cotton may be less breathable in hot summer months for sensitive sleepers.
- Price may be higher compared to standard sheets, although reflective of luxury quality.
LBRO2M Egyptian Cotton Sheets Set (Queen, 4 Pieces)

Seeking bedding that combines luxury, durability, and year-round comfort? The LBRO2M Egyptian Cotton Sheets Set (Queen, 4 Pieces) delivers just that. Made from 100% Egyptian cotton with a 1000-thread count, these sheets are soft, breathable, and built to last. The percale weave with a sateen finish gives a crisp, luxurious feel, while fully elasticized fitted sheets with deep pockets ensure a snug fit on most mattresses. They’re cool in summer and warm in winter, with minimal wrinkling and easy care. Though some find the pockets shallow for thicker beds, overall, this set offers hotel-quality comfort at a competitive price.
Best For: those seeking luxurious, breathable, and durable bedding that maintains comfort across all seasons and offers hotel-quality softness at an affordable price.
Pros:
- Made from 100% Egyptian cotton with a high 1000-thread count for exceptional softness and durability
- Features a crisp percale weave with a sateen finish, providing a luxurious, smooth feel
- Fully elasticized fitted sheet with deep pockets (up to 16 inches) ensures a secure fit on most mattresses
Cons:
- Pockets may be too shallow for very thick or plush mattresses and toppers
- Some users report wrinkles after washing and minor elastic strength issues over time
- Slight variations in color and potential for ripping after multiple washes according to some reviews
SGI 1000 Thread Count Egyptian Cotton King Sheet Set

Crafted for those who demand both luxury and durability, the SGI 1000 Thread Count Egyptian Cotton King Sheet Set delivers a premium sleep experience. Made from 100% Egyptian cotton with a dense, silky-smooth sateen weave, these sheets feel luxurious against the skin. The 4-piece set includes a generous flat sheet, deep-pocket fitted sheet, and two pillowcases, ensuring a perfect fit for mattresses up to 15 inches deep. Naturally breathable and moisture-wicking, they keep you comfortable year-round. Fade-resistant and easy to care for, these sheets maintain their vibrant color and softness wash after wash, offering lasting elegance and performance.
Best For: those seeking luxurious, durable, and easy-care sheets that offer a hotel-quality sleep experience for the king-sized bed.
Pros:
- Made from 100% Egyptian cotton with a 1000 thread count for superior softness and durability
- Includes a deep-pocket fitted sheet suitable for mattresses up to 15 inches deep, ensuring a snug fit
- Naturally breathable and moisture-wicking, providing year-round comfort in all seasons
Cons:
- May require ironing to maintain a crisp, smooth appearance after washing
- Higher price point due to premium materials and craftsmanship
- Sateen weave may feel warmer in hot climates if not properly ventilated
Threadmill Luxury Queen Sheet Set (800 Thread Count, 4 Pieces)

If you prioritize luxurious softness and long-lasting durability in your bedding, the Threadmill Luxury Queen Sheet Set (800 Thread Count, 4 Pieces) is an excellent choice. Crafted from pure cotton sateen with an 800 thread count, these sheets offer a silky, hotel-quality feel that’s breathable and resilient. Made from extra long staple cotton yarns, they resist pilling, fading, and shrinking, ensuring lasting comfort. The set includes a fitted sheet with deep pockets, a flat sheet, and pillowcases, all designed for a snug fit. Eco-friendly and certified OEKO TEX, they combine elegance with sustainability, making them a perfect upgrade for restful, restorative sleep.
Best For: those seeking luxurious, durable, and eco-friendly bedding that provides a silky, hotel-quality sleep experience.
Pros:
- Made from 800 thread count pure cotton sateen for exceptional softness and durability
- Features all-around elastic fitted sheet with deep pockets for a secure fit on queen beds
- Environmentally friendly, OEKO TEX certified, and manufactured in sustainable facilities
Cons:
- Higher price point may be a consideration for budget-conscious buyers
- White solid color may show stains more easily and require careful maintenance
- Care instructions recommend tumble drying on low, which may require additional attention to avoid wrinkles
SONORO KATE Egyptian Cotton Sheet Set, 4 Piece (Beige, King)

Are you looking for a bedding set that combines luxurious comfort with durability? The SONORO KATE Egyptian Cotton Sheet Set in beige offers just that. With a 1000 thread count and 100% Egyptian cotton, these sheets deliver exceptional softness, breathability, and temperature regulation for a cool, restful sleep. Designed to fit deep mattresses up to 24 inches, they stay snug thanks to a 360° elasticized fitted sheet. Easy to care for, they’re machine washable, wrinkle-resistant, and eco-friendly, certified by OEKO-TEX and GOTS. Highly rated for quality and comfort, this set elevates any bedroom with its modern, sophisticated look.
Best For: individuals seeking luxurious, breathable, and durable bedding that fits deep mattresses and adds sophistication to their bedroom décor.
Pros:
- Luxurious 1000 thread count Egyptian cotton for superior softness and comfort
- Fits up to 24-inch deep mattresses with a secure 360° elasticized fitted sheet
- Eco-friendly, OEKO-TEX and GOTS certified, ensuring safe and sustainable materials
Cons:
- Higher price point due to premium quality and certifications
- May require low heat ironing to maintain crisp appearance
- Limited color options, primarily available in solid beige
TEXAS LINEN CO. Egyptian Cotton King Size Sheets Set

The TEXAS LINEN CO. Egyptian Cotton King Size Sheets Set is a luxurious choice for those seeking hotel-quality bedding at home. Made from 100% Egyptian cotton with extra long staple fibers, these sheets offer exceptional softness and durability. The 1200 thread count and lustrous sateen weave create a silky, smooth feel that looks elegant and feels comfortable. Designed for year-round use, they’re breathable and resistant to pilling and fading thanks to mercerization. The set includes four pieces—fitted sheet, flat sheet, and two pillowcases—with a deep pocket that fits mattresses up to 19 inches thick. Perfect for elevating your sleep experience.
Best For: those seeking luxurious, hotel-quality bedding that combines softness, durability, and timeless elegance for all-season comfort.
Pros:
- Crafted from 100% Egyptian cotton with a 1200 thread count for luxurious softness and durability
- Features a lustrous sateen weave that adds elegance and a smooth, silky feel
- Mercerized treatment ensures color retention, resistance to pilling and fading, and long-lasting brightness
Cons:
- Naturally wrinkles after washing, requiring light ironing for a smooth finish
- May be heavier than standard sheets, which might not suit those preferring lightweight bedding
- Slightly higher price point compared to basic sheet sets, reflecting premium quality
FADFAY Shabby Floral Bedding Set (King Size)

For those seeking a blend of elegance and durability, the FADFAY Shabby Floral Bedding Set in king size stands out as an ideal choice. I love the delicate peony patterns on soft Egyptian cotton that feel luxurious against my skin. The set includes a spacious flat sheet, a fitted sheet with deep elasticized pockets, and matching shams, all crafted for a perfect fit. Its vibrant, fade-resistant colors stay beautiful wash after wash, and the breathable fabric ensures restful sleep. Plus, it’s easy to care for—machine washable and dryable—making it practical for everyday use. This set truly combines style, comfort, and quality effortlessly.
Best For: individuals seeking a luxurious, durable, and easy-care bedding set with elegant floral design for a restful night’s sleep.
Pros:
- Crafted from 100% Egyptian cotton for exceptional softness and breathability
- Deep pocket fitted sheet with elastic all around for a secure, snug fit
- Vibrant, fade-resistant colors that maintain their beauty wash after wash
Cons:
- Pattern alignment on the flat sheet may vary, requiring careful inspection before purchase
- May be more expensive than polyester or lower-quality bedding options
- The large size and deep pockets might require more storage space and handling
TEXAS LINEN CO. Egyptian Cotton King Sheets Set

If you’re seeking a luxurious, hotel-quality sleep experience at home, the TEXAS LINEN CO. Egyptian Cotton King Sheets Set is an excellent choice. Made from 100% Egyptian cotton with extra-long staple fibers, it offers unmatched softness, durability, and breathability. The 1500 thread count and sateen weave give the sheets a silky, lustrous feel that’s both smooth and inviting. Designed to keep you cool, these sheets are perfect for hot sleepers or those prone to night sweats. The set includes four pieces with deep pockets and easy-open pillowcases, all OEKO-TEX certified for safety and long-lasting quality.
Best For: Hot sleepers, those seeking a luxurious hotel-quality sleep experience at home, and individuals who value durable, breathable, and easy-care bedding.
Pros:
- Crafted from 100% Egyptian cotton with extra-long staple fibers for supreme softness and durability
- 1500 thread count and sateen weave provide a silky, lustrous, and smooth feel
- Designed to keep sleepers cool and breathable, ideal for hot sleepers and night sweats
Cons:
- Higher thread count sheets can sometimes feel heavier or more substantial than lightweight options
- Requires proper care to maintain brightness and softness over time
- May be more expensive than standard sheet sets due to high-quality materials and craftsmanship
Egyptian Cotton Sheets King Size (4 Pc Luxury Set)

Experience the pinnacle of comfort with our Egyptian Cotton Sheets King Size (4 Pc Luxury Set), designed for those who prioritize restful, hotel-quality sleep at home. Made from 100% Egyptian cotton with a 1000 thread count, these sheets are incredibly soft and silky smooth. The deep-pocket fitted sheet fits mattresses up to 16 inches deep, ensuring a snug, wrinkle-free fit. Breathable and temperature-regulating, they keep you cool in summer and warm in winter. The elegant ivory color adds a touch of luxury, while the durable fabric resists pilling and fading. Easy to care for, this set transforms your bed into a cozy, sophisticated retreat every night.
Best For: those seeking luxurious, hotel-quality sleep at home with durable, breathable, and elegant bedding.
Pros:
- Made from 100% Egyptian cotton with a high 1000 thread count for supreme softness and smoothness
- Deep-pocket fitted sheet fits mattresses up to 16 inches deep for a perfect, wrinkle-free fit
- Breathable and temperature-regulating fabric ensures comfort throughout all seasons
Cons:
- Higher price point due to premium materials and craftsmanship
- Ivory color may show stains more easily, requiring careful laundering
- May require ironing to maintain the crisp, hotel-quality appearance
Ashton Egyptian Cotton Sheets King Size (4 Pc, 1500 Thread Count, White, Sateen Weave)

The Ashton Egyptian Cotton Sheets are an ideal choice for those who demand hotel-quality luxury in their own home. Crafted from 100% Egyptian cotton with extra long staple fibers, they offer exceptional softness and durability. The 1500 thread count creates a silky, luxurious feel, enhanced further by a mercerized finish that adds luster and resists pilling. These heavyweight sheets are breathable, moisture-wicking, and perfect for all seasons, making hot sleepers comfortable. The deep pockets fit mattresses up to 19 inches thick, and the set includes pillowcases with open closures for oversized pillows. Overall, they deliver elegant style and long-lasting comfort.
Best For: Those seeking luxurious, hotel-quality bedding that combines softness, durability, and elegant design for year-round comfort.
Pros:
- Made from 100% Egyptian cotton with a 1500 thread count for exceptional silkiness and durability.
- Features a mercerized finish that enhances luster, brightens colors, and resists pilling and fading.
- Heavyweight, breathable, and moisture-wicking, suitable for all seasons and hot sleepers.
Cons:
- May require light ironing to reduce wrinkles and maintain a smooth appearance.
- Heavyweight feel might be less suitable for those preferring lightweight sheets.
- Deep pockets accommodate mattresses up to 19 inches, which may not fit thinner mattresses perfectly.
Factors to Consider When Choosing Luxury Bedding Sets Egyptian Cotton

When selecting luxury Egyptian cotton bedding, I focus on several key factors to make certain of quality and comfort. Understanding thread count, material quality, and weave type helps me choose the best set, while a deep pocket fit guarantees proper coverage. Additionally, considering care and maintenance ensures my bedding stays luxurious for years to come.
Thread Count Significance
Choosing the right thread count for Egyptian cotton bedding is vital because it directly affects the sheets’ softness, durability, and breathability. Generally, a thread count between 300 and 800 offers the best balance of these qualities, making sheets comfortable and long-lasting. Higher thread counts, like 1000 or more, may feel smoother but don’t always mean better quality; they can be denser and less breathable, trapping heat and reducing comfort. Conversely, extremely low counts might lack durability. It’s important to remember that thread count isn’t the only factor—fiber quality and weaving technique play essential roles in sheet performance. Ultimately, focusing on a moderate thread count within the ideal range ensures a luxurious, breathable sleep environment without sacrificing comfort or longevity.
Material Quality Assurance
Selecting high-quality Egyptian cotton for luxury bedding involves more than just looking at thread count; verifying the material’s authenticity and quality is key. Certified Egyptian cotton guarantees long-staple fibers, which translate into softness, durability, and breathability—essential qualities for a restful sleep. I also pay attention to certification labels like OEKO-TEX or GOTS, as they ensure the bedding is free from harmful chemicals and environmentally friendly. A high thread count, such as 1000 or above, indicates dense weaving that enhances strength and a silky feel. Proper finishing processes like mercerization improve color retention and resistance to pilling, extending the life of the bedding. Ensuring these factors helps me select bedding that’s not only luxurious but also safe and long-lasting.
Weave Type Difference
The type of weave in Egyptian cotton bedding considerably influences its look, feel, and performance, so understanding the differences helps me pick the right set. Sateen weave has a smooth, lustrous surface with a silky finish, creating a luxurious, hotel-like appearance. It’s softer and heavier, offering a plush feel, but it can be more prone to pilling over time. Conversely, percale weave offers a crisp, matte texture with a lightweight, breathable quality, making it ideal for hot sleepers. Percale sheets are durable, with a cool, invigorating feel that maintains its crispness wash after wash. Knowing these differences helps me choose based on my preferences for comfort, appearance, and longevity, ensuring I get the perfect Egyptian cotton bedding set tailored to my sleep style.
Deep Pocket Fit
When shopping for Egyptian cotton bedding, ensuring a proper fit is just as important as choosing the right weave. Deep pockets, typically between 15 to 19 inches, are essential for a secure, snug fit on thicker mattresses and toppers. Look for fully elasticized sheets, which offer flexibility and help prevent slipping or bunching during the night. Properly fitting deep pockets also maintain the sheet’s shape, reducing the need for constant readjustments. This feature is especially important for adjustable or pillow-top mattresses, which tend to be higher and require extra fabric. Choosing sheets with deep pockets not only enhances comfort but also keeps your bed looking neat and inviting throughout the night. A good fit is key to enjoying the full luxury of Egyptian cotton bedding.
Care & Maintenance
Proper care is essential to maintain the softness, durability, and luxurious appearance of Egyptian cotton bedding sets. I recommend machine washing them in cold water with a mild detergent to preserve their vibrant color and silky feel. Tumble drying on low heat or air drying helps prevent shrinkage and keeps the fabric in top condition. After drying, folding immediately reduces wrinkles and maintains the bedding’s smooth, elegant look. It’s important to avoid bleach and harsh chemicals, as they weaken fibers and diminish the fabric’s natural luster over time. Always follow the manufacturer’s care instructions, including gentle cycles and appropriate drying settings, to ensure your bedding remains beautiful and long-lasting. Proper maintenance keeps your Egyptian cotton sheets looking and feeling luxurious for years to come.
Breathability & Comfort
Choosing the right Egyptian cotton bedding set involves more than just looking at the size and design; breathability and comfort play a vital role in ensuring a restful night’s sleep. Egyptian cotton with a sateen weave offers a silky-smooth surface that feels luxurious but still promotes airflow. Its natural fiber structure creates mesh holes that enhance air circulation and help regulate temperature. Higher thread counts, like 1000 or more, result in denser fabrics that retain softness while remaining breathable. Properly woven Egyptian cotton sheets wick away moisture and prevent overheating, making them suitable for any season. Breathable bedding reduces night sweats and keeps you cooler through the night, ensuring a more comfortable, restorative sleep environment.
Eco-Friendly Certifications
Eco-friendly certifications like OEKO-TEX Standard 100 and GOTS are essential indicators of sustainable and safe Egyptian cotton bedding. These labels verify the bedding is free from harmful chemicals, making it safer for both your health and the environment. They also confirm that the manufacturing process follows strict environmental and social standards, such as using eco-conscious dyes and sustainable farming practices. Certified Egyptian cotton bedding is often produced with renewable energy sources and low-impact methods, reducing its ecological footprint. Additionally, these certifications support fair labor practices and responsible sourcing of long-staple cotton. Choosing bedding with recognized eco-certifications not only promotes sustainability but also aligns with health-conscious values, giving you peace of mind that your luxury set is environmentally friendly and responsibly made.
Frequently Asked Questions
How Do Egyptian Cotton Bedding Sets Influence Sleep Quality?
Egyptian cotton bedding sets considerably improve my sleep quality by offering exceptional softness and breathability. They regulate temperature, keeping me cool on warm nights and cozy when it’s colder. The durability means I don’t wake up with wrinkles or irritation. Overall, I find that sleeping on high-quality Egyptian cotton enhances my comfort, helping me fall asleep faster and wake up feeling refreshed and rested every morning.
Are Higher Thread Counts Always Better for Comfort?
Higher thread counts aren’t always better for comfort. I’ve found that while they can feel smoother and more luxurious, extremely high counts may reduce breathability, making the fabric less breathable and potentially less comfortable, especially if you tend to sleep hot. I recommend choosing a balanced thread count—around 300 to 400—that offers softness without sacrificing airflow. Ultimately, comfort depends on personal preference and fabric quality.
How Should I Care for Luxury Egyptian Cotton Sheets?
Caring for luxury Egyptian cotton sheets is like tending to a fine garden—they thrive with gentle attention. I wash mine in cold water on a delicate cycle, avoiding bleach and fabric softeners that can weaken fibers. Tumble dry low or line dry to preserve softness. Regularly folding and rotating them keeps them looking plush and feeling crisp, ensuring your sleep remains as luxurious as the sheets themselves.
What Are the Environmental Impacts of Egyptian Cotton Production?
Egyptian cotton production can have significant environmental impacts, including water usage and pesticide use. I’ve found that some farms rely heavily on chemical treatments, which can harm ecosystems. However, I prefer to choose brands that practice sustainable farming and organic methods. By supporting those, I feel better about my purchase, knowing I’m helping reduce environmental harm and promote eco-friendly practices in cotton cultivation.
Can Luxury Egyptian Cotton Bedding Improve Allergy Symptoms?
Think of luxury Egyptian cotton bedding as a gentle shield against allergies. I’ve found that these high-quality fabrics are often less likely to harbor dust mites and allergens because their long fibers create a smoother, tighter weave. This means fewer places for allergens to settle, helping me breathe easier at night. If you’re sensitive, investing in premium Egyptian cotton bedding could be a game-changer for your allergy relief.
Conclusion
Choosing the perfect Egyptian cotton bedding is like finding a rare gem — luxurious yet comforting. While some sets boast high thread counts and silky sateen weaves, others emphasize timeless elegance and durability. Remember, it’s not just about the price or label, but how it makes you feel. After all, a good night’s sleep isn’t just about luxury; it’s about waking up refreshed and ready to face the day.